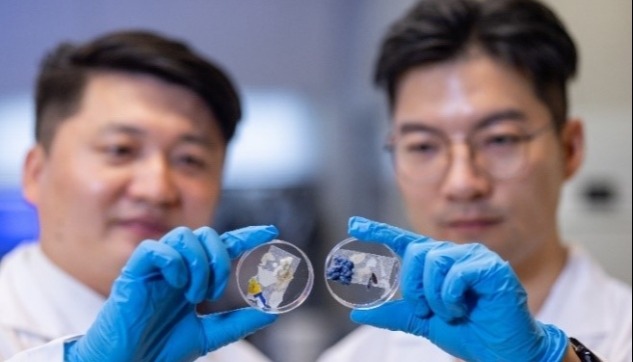

港中大發明可自然降解的包裝材料取代塑料分享到:
香港新聞網11月17日電 香港中文大學最新公佈,中大理學院助理院長(研究)兼化學系教授魏濤教授領導的研究團隊,在新一代可降解材料研究上取得重大突破。他們成功研發嶄新的可食用食品包裝膜,以取代塑膠。
塑膠袋是最常用的包裝材料,具有輕便、堅固、耐用、耐腐蝕和低成本等特點,但因為它需要數百年才可降解,被肆意丟棄的塑膠袋造成嚴重的環境污染。除了動物因誤食塑膠垃圾而死亡,進入食物鏈的塑膠顆粒更會破壞整個生態系統。面對不斷惡化的環境問題,研究人員正積極尋找可降解的生物質,例如植物纖維和從農業廢物中提取的生物聚合物等物料以替代塑膠。 魏教授及其團隊發現細菌纖維素(bacterial cellulose,簡稱BC)能用作可食用食品包裝膜。這種新生物基包裝材料的拉伸效果與塑膠袋類似,能在自然環境下降解,對人體無害,甚至可以直接食用。BC由木麴菌與酵母菌的共生菌體製造而成,這種共生菌體原用於製作康普茶(Kombucha),通稱“紅茶菌”。透過對木麴菌進行基因改造,使其分泌出纖維素,形成生物膜,經過微生物發酵後便成為BC。生產過程中無需砍伐樹木來提取植物細胞壁中的纖維素,不會對環境造成破壞。 研究團隊發現,由BC基薄膜、大豆蛋白、海藻酸鹽組成的複合材料,不但可食用,還具備力學穩定、透明、柔韌、高阻隔、高熱穩定性等多個優點。與需要在特定溫度的堆肥環境下才可分解的PLA(玉米澱粉樹酯,一種常見的生物可降解塑膠材料)不同,BC薄膜於一至兩個月內可在自然環境中完全降解,並適用於包裝高油分的調味料。這種方法製造出的BC薄膜不含有毒溶劑和添加化合物,在乾、濕狀態下同樣穩定,且生產過程簡單,有望取代商業塑膠,無毒特性亦使其適合用於食品包裝。 魏教授表示,這種材料絕對可安全食用,就算進入水生態,也不會對海龜等海洋生物構成威脅。這只是研究BC薄膜的起點,我們將繼續改進這種材料的多功能性,尤其是其熱塑性,以製作新型薄膜或塗層,供業界更廣泛的應用。他希望這種新型BC食品包裝膜可以為本地餐飲業界提供一個環保的選擇,為即將實施的即棄膠餐具管制措施作好準備。 (完) 【編輯:徐嘉儀】
相關新聞 |
視頻更 多
“半年前就已規劃五一來香港!”內地遊客跟著社交平台打卡黃金周
【你不知道的香港】五一來香港 留點時間給這五處山海秘境
貴州“村T”閃耀香港T台!從大山到國際時尚舞台 “村民模特隊”讓世界看見中國非遺之美
刷新全球車展規模紀錄!2026北京國際車展不止於“車”
“踢”碎刻板印象!巴西教練:從U7到U12香港足球可以踢任何歐洲隊
【通說環球】“天宮”開門迎客 中國太空“朋友圈”不斷擴大
【LIVING IN HONG KONG】背景不同但目標一致 是欖球讓他們一起打拼並愛上香港
來論更 多評論更 多
論壇更 多閱讀排行
|